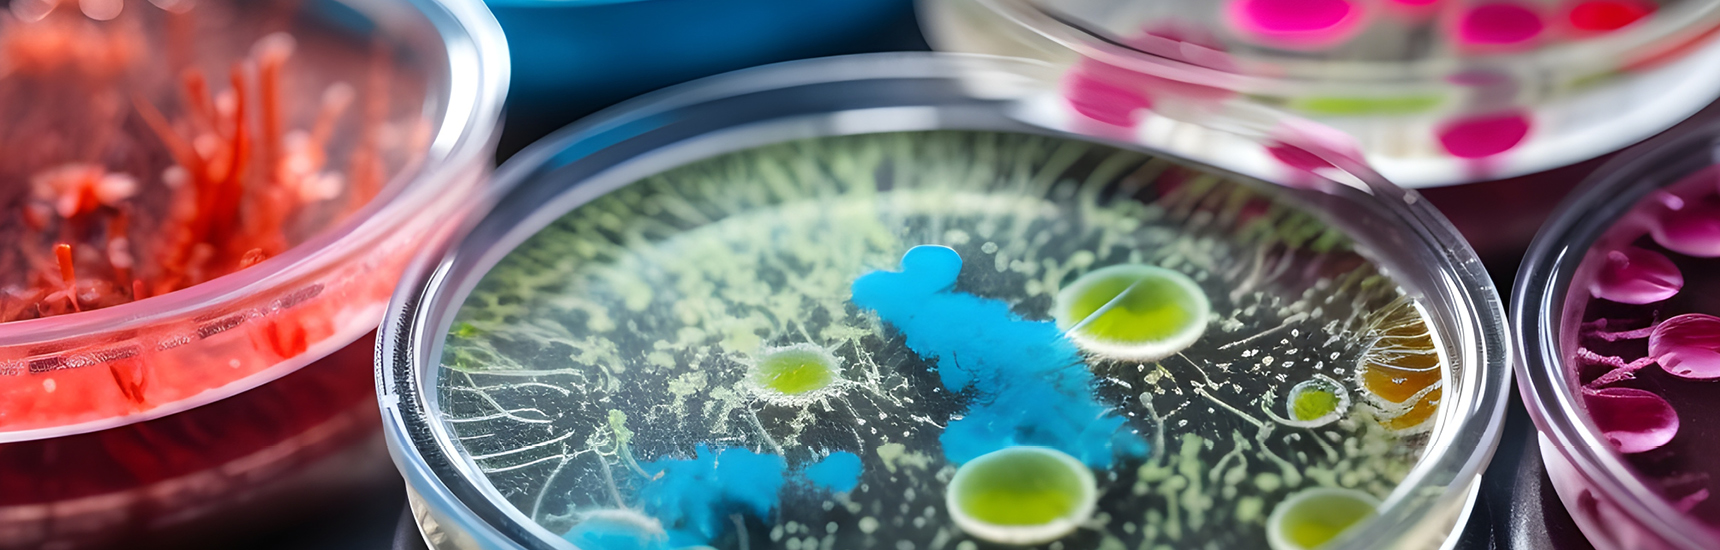
Pilzinfektionen können gefährlich werden - Foto: Siarhei/AdobeStock.com

Martin Hönigl im Gespräch: Die Pilze, die uns krank machen
Pilzinfektionen, sogenannte Mykosen, können zu schweren gesundheitlichen Problemen führen können. Und sie werden häufiger: „Pilzinfektionen nehmen kontinuierlich seit Jahren zu, trotz aller Maßnahmen, die wir ergreifen“, sagt Martin Hönigl, Professor für Translationale Mykologie an der Klinischen Abteilung für Infektiologie der Med Uni Graz.
Auch die WHO spricht in Zusammenhang mit Pilzinfektionen von einer der „größten Bedrohungen“, die Med Uni Innsbruck hat kürzlich ein neues Doktoratsprogramm gestartet, das sich dem Thema Resistenzen gegen Pilzmedikamente widmet. 130.000 Menschen erkranken in Österreich jedes Jahr an Pilzinfektionen. Sehr häufig handelt es sich dabei um Personen, deren Immunsystem geschwächt ist, etwa weil sie eine Krebstherapie durchlaufen. Bei immunsupprimierten Menschen ist demnach das Risiko, an einer Mykose zu erkranken, erhöht.
Schimmelpilzsporen, zum Beispiel jene der Aspergillus-Gruppe, können via Inhalation in den Körper gelangen, das kann auch außerhalb eines Krankenhauses passieren, wenn wir im Wald spazieren gehen, oder den Biomüll in die Tonne werfen.
Wieso Pilzinfektionen stetig zunehmen
Der Anstieg der Krankheitsfälle mit Pilzinfektionen hat zwei Gründe. Ersterer ist eigentlich ein guter, nämlich der Fortschritt in der Medizin. „Wir können immer mehr Krankheiten behandeln“, erklärt Hönigl. Menschen überleben diese, und leben auch länger. Betroffene würden Lebensphasen erreichen, in denen sie anfälliger für Pilzinfektionen werden – auch schwere, die mitunter tödlich verlaufen können. Häufig ist eine solche Infektion auf Intensivstationen zu beobachten.
Der zweite Grund ist der Klimawandel. Zwar gibt es unzählige Pilzarten, einige davon leiden auch unter dem Klimawandel, denn die meisten von ihnen bevorzugen es eher kühl oder feucht, aber „Pilze sind sehr anpassungsfähig“, sagt Hönigl. „Sie können sich an höhere Temperaturen adaptieren, was zu einem Problem werden kann, wenn es zu Temperaturen kommt, die unserer Körpertemperatur ähneln.“ Dadurch können neue Pathogene entstehen, Candida auris, ein Hefepilz, ist ein Beispiel dafür. Dieser kann Harnwegsinfektionen oder auch Blutvergiftungen hervorrufen, ist aber gegen viele herkömmliche Antipilztherapien resistent. Erstmals entdeckt wurde er 2009, binnen der letzten 17 Jahre hat er sich praktisch weltweit ausgebreitet.
Unendliche Infektionsherde
Infizieren kann man sich mit Pilzen praktisch überall. Denn verschiedenste Pilzsporen befinden sich in der Luft, der wir jeden Tag ausgesetzt sind. Pilzinfektionen treten also nicht in Spitälern auf. „Schimmelpilzsporen, zum Beispiel jene der Aspergillus-Gruppe, können via Inhalation in den Körper gelangen, das kann auch außerhalb eines Krankenhauses passieren, wenn wir im Wald spazieren gehen, oder den Biomüll in die Tonne oder auf den Komposthaufen werfen“, erklärt Hönigl. Aus diesem Grund rät er schwer immunsupprimierten Patienten, bei einem Waldspaziergang Maske zu tragen. Denn binnen Stunden kann sich Aspergillus bei diesen Patienten im Körper ausbreiten.
Pilzinfektionen in Österreich
130.000 Menschen erkranken in Österreich jährlich an Pilzinfektionen, die im schlimmsten Falle tödlich enden können. Zu den Risikogruppen zählen vor allem Menschen, deren Immunsystem geschwächt ist.
Bei gesunden Personen, deren Immunsystem funktioniert, ist Kontakt mit Pilzsporen kein gröberes Problem, die Erregerzellen werden einfach eliminiert. Anders sei dies, wenn Pilzinfektionen bei immungeschwächten oder mit Antibiotika behandelten Patienten auftreten würden – dann könnten sich diese ausbreiten. Ähnliches kennt man auch bei Asthma- oder COPD-Patienten. Wenn diese Cortison inhalieren, kann es zu schmerzhaften Pilzinfektionen mit Candida im Rachen und Mundraum kommen. Vorbeugen kann man einer Infektion, indem man nach dem Inhalieren mit Wasser nachspült oder kurz vor dem Essen inhaliert.
Textnachweis: Martina Marx, Kleine Zeitung vom 04.05.2024